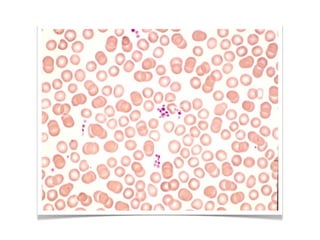

Blood is composed of cells suspended in plasma. The main cells are red blood cells (RBCs), which carry oxygen, white blood cells (WBCs), which fight infection, and platelets, which help with clotting. RBCs are produced through erythropoiesis in the bone marrow and contain hemoglobin to carry oxygen. WBCs include neutrophils, lymphocytes, monocytes, eosinophils, and basophils which protect the body. Conditions like anemia and leukemia can affect blood cell counts.